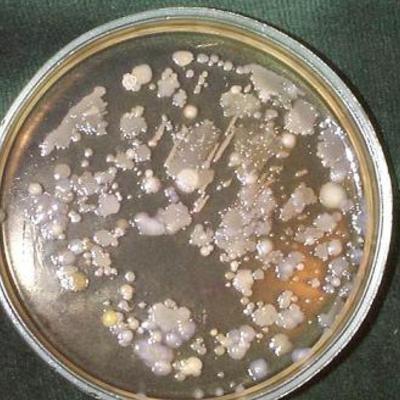
Main image001

К.х.н. О.В. Мосин
Тяжёлая вода отличается от обычной воды молекулярной массой. В молекуле тяжёлой воды в отличие от обычной воды вместо двух атомов водорода, связанных ковалентной связью с атомом кислорода в молекуле эти два атома водорода замещены на дейтерий.
Атом дейтерия отличается от атома водорода тем, что кроме протона он содержит нейтрон. Различие в нуклеарной массе атомов водорода и дейтерия и определяет те гидрофобные эффекты, которые тяжёлая вода оказывает на клетки и организм.
Важной проблемой для биосинтеза является адаптация клетки к тяжёлой воде. Долгое время считалось, что тяжёлая вода несовместима с жизнью. Известно, что высокие концентрации тяжёлой воды в ростовой среде могут вызвать ингибирование жизненно-важных функций роста и развития многих микроорганизмов [1].
Однако, несмотря на негативный биостатический эффект, оказываемый тяжёлой водой на клетки, некоторые бактерии устойчивы к высоким концентрациям тяжёлой воды в среде [2], в то время как растительные клетки могут нормально развиваться при концентрациях не более 50-75% тяжёлой воды [3], а клетки животных не более 35% тяжёлой воды [4].
Мы задались вопросом - каков механизм клеточной адаптации к тяжёлой воде и могут ли клетки быть успешно адаптированы к росту и биосинтезу на средах с максимальными концентрациями тяжёлой воды?
Для решения этого вопроса мы выбрали для экспериментов бактериальные штаммы-продуценты аминокислот, белков и нуклеозидов, относящиеся к различным таксономическим родам микроорганизмов, полученных из Всероссийской коллекции промышленных микроорганизмов (ВКПМ) Государственного научно-исследовательского института генетики и селекции промышленных микроорганизмов:
1. Brevibacterium methylicum ВКПМ В 5652, лейцинзависимый штамм факультативных метилотрофных бактерий, продуцент фенилаланина.
2. Methylobacillus flagellatum КТ, изолейцинзависимый штамм облигатных метилотрофных бактерий, продуцент лейцина.
3. Bacillus subtilis В-3157, полиауксотрофный по гистидину, тирозину, аденину и урацилу бациллярный штамм грамотрицательных бактерий, продуцент инозина.
4. Halobacterium halobium ЕТ 1001, пигментсодержащий штамм галофильных бактерий, способный синтезировать бактериородопсин.
Стартовым материалом для культивирования галофильных бактерий и бацилл служила дейтеро-биомасса метилотрофных бактерий Brevibacterium methylicum, полученная в условиях многостадийной адаптации на твердых агаризованных средах (2% агар) с 2% дейтеро-метанолом, содержащих ступенчато увеличивающийся градиент концентрации тяжёлой воды (от 0 до 98% тяжёлой воды).
Полученную таким образом дейтеро-биомассу B. methylicum (выход составил 100 г по влажному весу с 1 л. среды) автоклавировали в 0.5 н. растворе дейтерохлорной кислоты (в тяжёлой воде) (08 ати, 30 мин), нейтрализовали 0.1 н. КОН (рН 7.0) и использовали далее в качестве источника субстрата для адаптации и культивирования бацилл и галофильных бактерий.
Культивировании клеток микроорганизмов проводили на трёх питательных средах (количества компонентов приведены в г/л):
1. Минимальная среда М9 для роста метилотрофных бактерий, на основе различных концентраций тяжёлой воды и добавками 0.5-2% метанола (в зависимости от физиологической потребности бактерий) или дейтеро-метанола: KH2PO4 3; Na2HPO4 6; NaCl 0.5; NH4Cl 1.
2. Гидролизная среда 1 (ГС1) для культивирования бацилл (на основе 99.9% тяжёлой воды): глюкоза 120; дейтеро-меченая биомасса B. methylicum 25; NH4NO3 30; MgSO4 x 7H2O 20; мел 20.
3. Гидролизная среда 2 (ГС2) для культивирования галофильных бактерий (на основе 99.9% тяжёлой воды): NaCl 250; MgSO4 x 7H2O 20; KCl 2; CaCl2 x 6H2O 0.065; цитрат натрия 0.5; дейтеро-меченая биомасса B. methylicum 20.
Культивирование метилотрофных бактерий и бацилл проводили при 370 С в колбах Эрленмейера вместимостью 250 мл с наполнением средой до 50 мл в условиях аэрации по методикам [5-8], используя в качестве источников дейтерия тяжёлую воду и дейтеро-метанол. Культивирование галофильных бактерий проводили на тяжеловодородной среде при освещении лампами дневного света ЛБ-40.
Для проведения адаптации был выбран ступенчатый режим увеличения концентрации тяжёлой воды в ростовых средах в присутствии 0.5-1%-ного метанола/дейтеро-метанола , так как мы предположили, что постепенное привыкание организма к дейтерию будет оказывать благоприятный эффект на параметры роста и общее самочувствие клеток.
Предложенный нами метод твёрдофазной адаптации состоит из серии множественных адаптационных пассажей исходной культуры на чашках Петри с твёрдыми агаризованными средами со ступенчатом увеличении концентрации тяжёлой воды в них (от 0 до 98% тяжёлой воды).
При этом на чашках Петри последовательно отбирались отдельные колонии, выросшие на средах, содержащих низкие концентрации тяжёлой воды. Затем их последовательно пересевали на твёрдые среды с большей степенью дейтерированности, включая среду с 98% тяжёлой водой (степень выживаемости бактерий на максимальной тяжёловодородной среде составила не более 50%).
Таким образом на чашках Петри с максимальной концентрацией тяжёлой водой были выделены отдельные клеточные клоны, каждые из которых представляли собой потомство отдой единственной клетки, устойчивой к действию тяжёлой воды.
При этом на чашках Петри последовательно отбирались отдельные колонии, выросшие на средах, содержащих низкие концентрации тяжёлой воды. Затем их пересевали на среды с большей степенью дейтерированности, включая среду с 98% тяжёлой водой (степень выживаемости бактерий на максимальной тяжёловодородной среде составила не более 50%).
За ходом адаптации клеток наблюдали по изменениям продолжительности лаг-фазы, времени клеточной генерации и выходов микробной биомассы, а также по максимальному уровню накопления конечных продуктов биосинтеза в культуральной жидкости. Рост бактерий оценивали по способности к образованию отдельных колоний на поверхности твёрдых агаризованных сред, а также по величине оптической плотности суспензии клеток, измеренной на спектрофотометре Beckman-DU6 (США) при 540 нм.
Первые опыты по адаптации клеток к тяжёлой воде привели к неудаче. Штамм M. flagellatum обнаружил повышенную чувствительность к тяжёлой воде: ингибирование скорости роста бактерий наблюдалось при концентрации тяжёлой воды в среде 74.5%, в то время как дейтеро-метанол не оказывал существенного влияния на скорость роста клеток. Так, на среде, содержащей 74.5% тяжёлую воду выход микробной биомассы составил 29%, что в 3.4 раза ниже, чем в контрольных экспериментах, когда использовали обычную воду и метанол, в то время как выход микробной биомассы на водной среде с 1%-ным дейтеро-метанолом был снижен всего лишь в 1.2 раза.
Попытки адаптировать другой штамм B. methylicum к росту на тяжёлой воде при сохранении способности к биосинтезу фенилаланина привели к положительному результату. При росте клеток B. methylicum на обычной воде продолжительность лаг-фазы не превышала 20 ч, в то время как с увеличением концентрации тяжёлой воды в ростовых средах до 98% продолжительность лаг-фазы увеличивалась до 60 часов.
Мы обнаружили, что длительность времени клеточной генерации с увеличением концентрации тяжёлой воды в ростовых средах постепенно увеличивается, достигая 4,9 часов на среде с 98% тяжёлой воды и 2% дейтеро-метанолом. В отличие от тяжёлой воды, дейтеро-метанол не вызывал ингибирования роста и не оказывал влияния на выходе микробной биомассы. Напротив, на максимально концентрированной тяжёлой воде водой выход микробной биомассы был снижен в 3.3 раза по сравнению с контролем.
Важно то, что выход микробной биомассы и уровень накопления фенилаланина в культуральной жидкости при росте адаптированного к тяжёлой воде микроорганизма в максимально концентрированной тяжёлой воде изменяются по сравнению с контрольными условиями на 13 и 5%, т. е. незначительно.
В следующих опытах была исследована способность к росту на тяжёлой воде бациллярного штамма B. subtilis, продуцента инозина. Рост данного штамма лучше всего происходил на ГС 1 среде, содержащей в качестве источника углерода глюкозу, а в качестве источника ростовых факторов гидролизаты дейтерий-меченой биомассы метилотрофных бактерий B. methylicum.
Данный штамм удалось адаптировать к тяжёлой воде путём рассева на твёрдую агаризованную среду ГС 1 с 99.9% тяжёлой воды. Он сразу обнаружил нормальный рост на тяжёлой воде.
При культивировании адаптированного B. subtilis на жидкой ГС 1 среде, уровень накопления инозина в культуральной жидкости снижается по-сравнению с исходным штаммом.
При росте исходного штамма B. subtilis на среде, содержащей обычную воду и протонированную биомассу уровень накопления инозина в культуральной жидкости достигал величины 17 г/л после пяти суток культивирования. Вместе с тем уровень накопления инозина на ГС 1 среде, был снижен в 4.4 раза по сравнению с исходным штаммом на протонированной среде.
Сниженный уровень продукции инозина на в этих условиях коррелирует со степенью конверсии глюкозы, которая на тяжёлой воде ассимилировалась не полностью, о чём свидетельствовали значительные количества накопленной в культуральной жидкости глюкозы после ферментации.
В случае с галофильной бактерией H. halobium адаптацию проводили как на агаре, содержащим 99.9% тяжёлую воду с добавлением гидролизатов дейтеро-меченой биомассы B. methylicum, путём рассева штамма до отдельных колоний, так и на жидкой ГС 2 среде. В обычных для этой культуры условиях культивирования (37 0С, на свету) в клетках синтезировался фиолетовый пигмент по всем характеристикам не отличающийся от нативного мембранного белка бактериородопсина.
Проведённые нами исследования свидетельствуют, что способность к адаптации к тяжёлой воде у разных родов и видов бактерий различная и может варьировать на примере метилотрофных бактерий в пределах даже одной таксономической группы. Из этого можно заключить, что адаптация к тяжёлой воде определяется как таксономической специфичностью микрооорганизмов, так и особенностями их метаболизма, функционированием различных путей ассимиляции субстратов, а также эволюционной нисшей, которую занимает исследуемый объект.
При этом чем ниже уровень эволюционного развития организма, тем лучше он приспосабливается к присутствию дейтерия в среде. Так, из изученных объектов самыми примитивными в эволюционном плане являются галофильные бактерии, относящиеся к археобактериям, практически не нуждающие в адаптации к тяжёлой воде, чего нельзя сказать о метилотрофных бактериях, которые труднее адаптируются к тяжёлой воде. Для всех изученных микроорганизмов рост на тяжёлой воде сопровождался снижением ростовых характеристик а также уровня продукции секретируемых БАС.
Полученные для изученных микроорганизмов данные в целом подтверждают устойчивое представление о том, что адаптация к тяжёлой воде является фенотипическим явлением, поскольку адаптированные к тяжелой воде клетки возвращаются к нормальному росту и биосинтезу в протонированных средах после некоторого лаг-периода.
По-видимому, метаболизм адаптированных клеток не претерпевает существенных изменений в тяжёлой воде. В то же время эффект обратимости роста на водно/тяжёловодородных средах теоретически не исключает возможности того, что этот признак стабильно сохраняется при росте в воде, но маскируется при переносе клеток на тяжёлую воду. Однако, здесь необходимо подчеркнуть, что для проведения адаптации играет немаловажную роль состав среды культивирования.
При этом не исключено, что при проведении адаптации на минимальных средах, содержащих тяжёлую воду образуются формы бактерий, ауксотрофные по определенным ростовым факторам, например аминокислотам, и вследствие этого бактериальный рост ингибируется. Адаптация к тяжёлой воде происходит лучше всего именно на комплексных средах, содержащих широкий набор ростовых факторов и аминокислот, компенсирующих потребность бактерий в этих соединениях.
Можно предположить, что клетка реализует лабильные адаптивные механизмы, которые способствуют функциональной реорганизации работы жизненно-важных систем в тяжёлой воде. Так, например, нормальному биосинтезу и функционированию в тяжёлой воде таких биологически активных соединений, как нуклеиновые кислоты и белки способствует поддержание их структуры посредством формирования водородных (дейтериевых) связей в молекулах.
Связи, сформированные атомами дейтерия различаются по прочности и энергии от аналогичных водородных связей. Различия в нуклеарной массе атома водорода и дейтерия косвенно могут служить причиной различий в синтезах нуклеиновых кислот, которые могут приводить в свою очередь к структурным различиям и, следовательно, к функциональным изменениям в клетке. Вероятнее всего, что ферментативные функции и структура синтезируемых белков также изменяются при росте клеток на тяжёлой воде, что может отразиться на процессах метаболизма и деления клетки.
Некоторые исследователи сообщают, что после обратного изотопного (1Н-2H)-обмена ферменты не прекращают своей функции, но изменения в результате изотопного замещения за счет первичного и вторичного изотопных эффектов, а также действие тяжёлой воды как растворителя (большая структурированность и вязкость по сравнению с обычной водой) приводили к изменению скоростей и специфичности ферментативных реакций в тяжёлой воде.
Структурно-динамические свойства клеточной мембраны, которые в большинстве зависят от качественного и количественного состава липидов, также могут изменяться в присутствии тяжёлой воды. Полученный результат объясняется тем, что клеточная мембрана является одной из первых органелл клетки, которая испытывает воздействие тяжёлой воды, и тем самым компенсирует реалогические параметры мембраны (вязкость, текучесть, структурированность) изменением количественного состава липидов.
В общих чертах, при попадании клетки в дейтерированную среду из неё не только исчезает протонированная вода за счет реакции обмена вода-тяжёлая вода, но и происходит очень быстрый изотопный (1Н-2H)-обмен в гидроксильных, карбоксильных, сульфгидрильных и аминогруппах всех органических соединений, включая нуклеиновые кислоты, липиды, белки и сахара.
Известно, что в этих условиях только С-Н связь не подвергается изотопному обмену и вследствие этого только соединения со связями типа С-D могут синтезироваться de novo.
Кроме вышеобозначенных эффектов, возможное изменение соотношения основных метаболитов в процессе адаптации к тяжелой воде также может негативно сказываться на рост клетки. Мы предположили, что эффекты, наблюдаемые при адаптации к тяжёлой воде связаны с образованием в тяжёлой воде конформаций молекул с иными структурно-динамическими свойствами, чем конформаций, образованных с участием водорода, и поэтому имеющих другую активность и биологические свойства.
Так, по теории абсолютных скоростей разрыв СH-связей может происходить быстрее, чем СD-связей, подвижность иона D+ меньше, чем подвижность Н+, константа ионизации тяжёлой воды несколько меньше константы ионизации обычной воды.
Суммируя полученные данные, мы сделали вывод, что чувствительности различных клеточных систем к тяжёлой воде отличны. С точки зрения физиологии, наиболее чувствительными к замене Н+ на D+ могут оказаться аппарат биосинтеза макромолекул и дыхательная цепь, т. е., именно те клеточные системы, которые используют высокую подвижность протонов и высокую скорость разрыва водородных связей.
Нам представляется выбор бактерий в качестве модельных объектов для данных исследований наиболее целесообразным, так как прокариоты как организмы, стоящие на более низких ступенях развития живого, наиболее лабильны в генетическом аспекте и тем самым быстрее реагируют и приспосабливаются к изменчивым факторам среды.
Список литературы:
1. Crespi H. L. Biosynthesis and uses of per-deuterated proteins. in: Synt. and Appl. of Isot. Label. Compd. // Ed. R. R. Muccino. - Elsevier. - Amsterdam, 1986 - P. 111-112.
2. Katz J, Crespi H.L. // Pure Appl. Chem. - 1972. - V.32. - P. 221-250.
3. Daboll H. F., Crespi H. L., Katz J. J. // Biotechnology and Bioengineering. - 1962. - V. 4. - P. 281-297.
4. Crespy H. L. Stable Isotopes in the Life Sciences. - International atomic energy agency. - Vienna. - 1977. - P. 111-121.
5. Мосин О. В., Карнаухова Е. Н., Пшеничникова А. Б., Складнев Д. А., Акимова О. Л. // Биотехнология. - 1993. - N 9. - С. 16-20.
6. Мосин О. В., Складнев Д. А., Егорова Т. А., Юркевич А. М., Швец В. И. // Биотехнология. - 1996. - N 3. - С. 3-12.
7. Мосин О. В., Складнев Д. А., Егорова Т. А., Швец В. И. // Биоорганическая химия. - 1996. - Т. 22. - N 10-11. - С. 856-869.
8. Складнев Д. А., Мосин О. В., Егорова Т. А., Ерёмин С. В., Швец В. И. // Биотехнология. - 1996. - N 5. - С. 25-34.